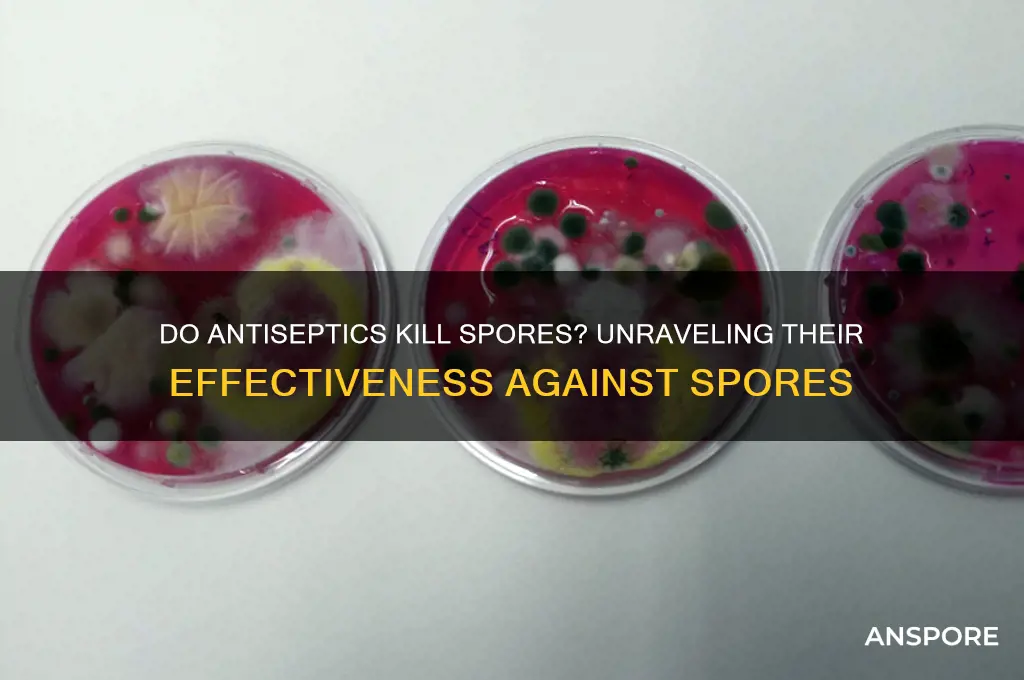
do antiseptics kill spores

Antiseptics are widely used to prevent infection by inhibiting the growth of microorganisms on living tissues, but their effectiveness against bacterial spores remains a critical question. Spores, particularly those produced by bacteria like *Clostridium difficile* and *Bacillus* species, are highly resistant structures designed to withstand harsh environmental conditions, including exposure to many antimicrobial agents. While antiseptics can effectively kill vegetative bacteria, their ability to eliminate spores is generally limited due to the spore’s robust outer coat and dormant metabolic state. Understanding this distinction is essential for appropriate use in medical and clinical settings, as reliance on antiseptics alone may not suffice in scenarios where spore-forming bacteria are present.
| Characteristics | Values |
|---|---|
| Effectiveness on Spores | Most antiseptics are ineffective against bacterial spores. Spores have a highly resistant structure due to their thick, impermeable outer coat (exosporium) and low water content, which protects them from many chemical agents. |
| Exceptions | Some specialized antiseptics, such as glutaraldehyde and hydrogen peroxide (at high concentrations), can kill spores, but they are not typically classified as standard antiseptics and require specific conditions for efficacy. |
| Mechanism of Resistance | Spores resist antiseptics due to their dormant state, low metabolic activity, and the presence of dipicolinic acid, which stabilizes their DNA and proteins against damage. |
| Common Antiseptics | Standard antiseptics like alcohol (ethanol, isopropanol), iodine, chlorhexidine, and quaternary ammonium compounds are generally ineffective against spores. |
| Clinical Relevance | In healthcare settings, spores (e.g., Clostridioides difficile) require sterilization methods (e.g., autoclaving) or sporicidal agents for effective elimination, as antiseptics alone are insufficient. |
| Sporicidal Agents | Agents like formaldehyde, peracetic acid, and high-temperature steam are required to kill spores, not typical antiseptics. |
| Conclusion | Antiseptics do not kill spores under normal conditions; sporicidal agents or sterilization methods are necessary for spore inactivation. |
Explore related products
$18.47 $25.87
What You'll Learn

Effectiveness of Antiseptics on Spores
Antiseptics are widely used for their ability to kill or inhibit the growth of microorganisms on living tissue, but their effectiveness against spores is a critical area of inquiry. Spores, particularly those produced by bacteria like *Clostridium difficile* and *Bacillus anthracis*, are highly resistant to many antimicrobial agents due to their robust outer coat and dormant metabolic state. Unlike vegetative cells, spores require more aggressive methods to eradicate, such as high temperatures or specialized chemicals like hydrogen peroxide at concentrations of 6% or higher. Standard antiseptics like ethanol (70%) or iodine (2%) are generally ineffective against spores, as they lack the penetrative power to disrupt the spore’s protective layers.
To understand why antiseptics often fail against spores, consider the spore’s structure. The outer exosporium and inner cortex act as barriers, while the core contains highly compacted DNA and enzymes that resist damage. Antiseptics typically work by denaturing proteins, disrupting cell membranes, or interfering with metabolic processes—mechanisms that are ineffective on dormant spores. For instance, alcohol-based hand sanitizers, which are effective against most bacteria and viruses, have little to no impact on spores. This limitation underscores the need for spore-specific treatments in medical and industrial settings, particularly in wound care and sterilization processes.
In clinical practice, the ineffectiveness of antiseptics against spores has significant implications. For example, in surgical settings, instruments must be sterilized using autoclaves (steam under pressure at 121°C) rather than antiseptic solutions to ensure spore destruction. Similarly, in healthcare, patients with *C. difficile* infections require contact precautions and environmental cleaning with spore-killing agents like chlorine-based disinfectants (e.g., 5,000–10,000 ppm sodium hypochlorite). Relying on antiseptics alone in such cases could lead to persistent contamination and recurrent infections, highlighting the importance of selecting the right agent for the target organism.
Despite their limitations, antiseptics can play a role in spore management when combined with other strategies. For instance, povidone-iodine (10% solution) has been shown to reduce spore counts when used in conjunction with mechanical debridement in wound care. Additionally, hydrogen peroxide-based antiseptics, when applied at high concentrations and prolonged exposure times, can achieve sporicidal activity. However, these approaches are not foolproof and require careful application, emphasizing the need for evidence-based protocols tailored to specific scenarios.
In summary, while antiseptics are invaluable tools for infection control, their effectiveness against spores is limited. Understanding the biological resilience of spores and the mechanisms of antiseptics allows for informed decision-making in medical, industrial, and household contexts. For spore-related concerns, alternative methods like heat, radiation, or specialized chemicals remain the gold standard. By recognizing these limitations, practitioners can ensure more effective disinfection and sterilization practices, ultimately improving safety and outcomes.
Can C. Diff Spores Be Inhaled? Understanding Airborne Transmission Risks
You may want to see also

Types of Spores Resistant to Antiseptics
Antiseptics are widely used to eliminate microorganisms, but not all spores succumb to their action. Certain spore-forming bacteria, such as *Clostridium difficile* and *Bacillus anthracis*, exhibit remarkable resistance due to their robust outer coats and slow metabolic rates. These spores can survive exposure to common antiseptics like alcohol-based solutions and iodine compounds, posing challenges in healthcare and industrial settings. Understanding which spores resist antiseptics is crucial for developing effective disinfection strategies.
Consider the spore structure of *Clostridium difficile*, a leading cause of hospital-acquired infections. Its outer layer, composed of proteins like SASP (spore-associated protein), provides a protective barrier against antiseptics. Studies show that even 70% isopropyl alcohol, a standard antiseptic, fails to inactivate *C. difficile* spores within the recommended contact time. To combat this, healthcare facilities often employ sporicidal agents like chlorine dioxide or hydrogen peroxide vapor, which require longer exposure times (e.g., 10–20 minutes) and higher concentrations (e.g., 500–1000 ppm) to ensure efficacy.
In contrast, *Bacillus anthracis*, the causative agent of anthrax, forms spores with a unique exosporium layer that resists desiccation and chemical agents. Traditional antiseptics like chlorhexidine (0.5–2% solutions) are ineffective against these spores, necessitating specialized decontamination protocols. For instance, environmental cleanup after anthrax exposure involves using high-concentration bleach (5000–10,000 ppm) or formaldehyde gas, which penetrate the spore’s protective layers over extended periods (e.g., 12–24 hours).
Practical tips for dealing with resistant spores include verifying the sporicidal claims of antiseptic products and ensuring proper application techniques. For example, alcohol-based hand sanitizers are ineffective against *C. difficile* spores, so handwashing with soap and water is recommended in healthcare settings. Additionally, rotating sporicidal agents can prevent the development of resistance in spore-forming bacteria. Always follow manufacturer guidelines for concentration, contact time, and surface compatibility to maximize effectiveness.
In summary, spores of *C. difficile*, *B. anthracis*, and other bacteria resist common antiseptics due to their protective structures and dormant metabolic states. Addressing this resistance requires targeted sporicidal agents, precise application methods, and adherence to evidence-based protocols. By understanding these specifics, individuals and organizations can better mitigate the risks posed by antiseptic-resistant spores in various environments.
Cold Spores Inoculation: Unlocking Benefits and Safety Considerations
You may want to see also

Mechanisms of Spore Survival Against Antiseptics
Spores, the dormant forms of certain bacteria, are notoriously resistant to antiseptics. This resilience stems from their unique structure and composition. Unlike vegetative cells, spores possess a thick, multi-layered coat composed of proteins and peptidoglycan, which acts as a formidable barrier against external agents. Additionally, the core of a spore contains high levels of calcium dipicolinate, a compound that binds water molecules, reducing the availability of liquid needed for chemical reactions that could otherwise damage the spore. This desiccated state further enhances their resistance to antiseptics, which often rely on aqueous environments to function effectively.
One key mechanism of spore survival is their ability to remain metabolically inactive. In this dormant state, spores are less susceptible to antiseptics that target active cellular processes, such as DNA replication or protein synthesis. For instance, antiseptics like chlorhexidine and povidone-iodine, which disrupt cell membranes and denature proteins, are far less effective against spores because these agents require metabolic activity to penetrate and cause damage. Even when spores are exposed to high concentrations of antiseptics (e.g., 10% povidone-iodine), their dormant nature allows them to withstand prolonged exposure without significant harm.
Another critical factor is the spore’s DNA repair mechanisms. Spores contain specialized proteins, such as small acid-soluble proteins (SASPs), which protect their DNA from damage. If an antiseptic does manage to penetrate the spore coat and cause DNA lesions, these repair mechanisms can quickly restore genetic integrity once the spore germinates. This ability to repair damage post-exposure is a significant advantage over vegetative cells, which lack such robust repair systems. For example, spores of *Bacillus subtilis* have been shown to survive exposure to hydrogen peroxide, a common antiseptic, by activating DNA repair pathways upon germination.
Practical strategies to enhance antiseptic efficacy against spores include combining agents with sporicidal properties, such as peracetic acid or glutaraldehyde, which can penetrate the spore coat and disrupt internal structures. Heat treatment, such as autoclaving at 121°C for 15 minutes, is also highly effective in destroying spores by denaturing their proteins and degrading their DNA. For surfaces, using a two-step process—cleaning with a detergent to remove organic matter followed by application of a sporicidal antiseptic—can improve outcomes. However, it’s crucial to follow manufacturer guidelines for concentration and contact time, as improper use may result in spore survival.
In summary, spores survive antiseptics through a combination of structural barriers, metabolic dormancy, and DNA repair mechanisms. While many antiseptics are ineffective against spores, understanding these mechanisms allows for the development of targeted strategies to enhance their destruction. Whether in medical, industrial, or domestic settings, combining sporicidal agents, heat treatment, and proper application techniques is essential for effective spore eradication.
How to Defeat a Spore Lizard: Effective Strategies and Tips
You may want to see also
Explore related products

Antiseptic Concentration and Spore Inactivation
Antiseptics are widely used for their ability to inhibit or destroy microorganisms, but their efficacy against spores remains a critical question. Spores, particularly bacterial endospores, are highly resistant to environmental stresses, including many antiseptic agents. The concentration of an antiseptic plays a pivotal role in determining its effectiveness against these resilient structures. For instance, common antiseptics like chlorhexidine gluconate and povidone-iodine are more effective at higher concentrations, typically above 2% and 10%, respectively. However, even at these levels, complete spore inactivation is not guaranteed, as spores can remain viable due to their protective coats and dormant metabolic state.
To achieve spore inactivation, the application method and duration are as crucial as concentration. For example, a 4% chlorhexidine solution applied for 10 minutes may reduce spore counts but not eliminate them entirely. In contrast, a 10% povidone-iodine solution requires at least 15 minutes of contact time to show significant sporicidal activity. These specifics highlight the need for precise protocols, especially in medical and industrial settings where spore contamination poses serious risks. Practitioners must balance higher concentrations with potential tissue toxicity, particularly in wound care or surgical applications.
A comparative analysis reveals that certain antiseptics, such as glutaraldehyde and hydrogen peroxide, are more effective against spores due to their ability to penetrate the spore coat. Glutaraldehyde at 2% concentration, for instance, can achieve spore inactivation within 10 minutes, making it a preferred choice in sterilization processes. Hydrogen peroxide, especially in vaporized form or at concentrations above 6%, demonstrates sporicidal activity by generating reactive oxygen species that damage spore DNA. However, these agents require careful handling due to their corrosive nature and potential health hazards.
Practical tips for optimizing antiseptic concentration and spore inactivation include pre-cleaning surfaces to remove organic debris, which can shield spores from antiseptic action. For example, in healthcare settings, using a 70% isopropyl alcohol solution as a preliminary step can enhance the efficacy of subsequent antiseptic treatments. Additionally, combining mechanical action, such as scrubbing or ultrasonic cleaning, with antiseptic application can improve spore eradication. Age-specific considerations are also important; for pediatric or geriatric populations, lower concentrations of antiseptics may be necessary to avoid skin irritation, even if it means compromising sporicidal efficacy.
In conclusion, while antiseptic concentration is a key factor in spore inactivation, it is not the sole determinant of success. The choice of antiseptic, application method, duration, and environmental conditions all play critical roles. For instance, in food processing, a 3% acetic acid solution may be effective against spores on surfaces but requires prolonged exposure. Understanding these nuances allows for tailored approaches that maximize sporicidal activity while minimizing risks. Always refer to manufacturer guidelines and regulatory standards to ensure safe and effective use of antiseptics in spore-prone environments.
Can Bulbasaur Learn Stun Spore? Exploring Moveset Possibilities
You may want to see also

Alternatives to Antiseptics for Spore Elimination
Antiseptics, while effective against many microorganisms, often fall short when it comes to eliminating spores due to their resilient nature. This limitation necessitates exploring alternative methods that can effectively target and destroy these persistent forms of life. Below are several strategies and solutions that offer viable alternatives to antiseptics for spore elimination.
Physical Methods: Heat and Radiation
One of the most reliable ways to kill spores is through the application of heat. Autoclaving, for instance, uses steam under pressure at 121°C (250°F) for 15–30 minutes, effectively destroying even the most resistant spores. This method is widely used in medical and laboratory settings. For smaller items or home use, boiling water at 100°C (212°F) for 10–15 minutes can also be effective, though less reliable for all spore types. Alternatively, ionizing radiation, such as gamma rays or electron beams, can break down spore DNA, rendering them inactive. This method is particularly useful in sterilizing medical equipment and food products but requires specialized equipment and expertise.
Chemical Alternatives: Sporicidal Agents
Certain chemicals are specifically designed to target spores, offering a more focused approach than general antiseptics. Chlorine dioxide, for example, is a powerful sporicidal agent effective at concentrations of 50–100 ppm for 8–24 hours, depending on the spore type. Hydrogen peroxide, especially in vaporized form (35–70% concentration), is another potent option, often used in healthcare settings for room decontamination. Peracetic acid, at 0.2–0.35%, is also highly effective against spores and is commonly used in the food and beverage industry. These agents require careful handling due to their corrosive nature and should be used in well-ventilated areas with appropriate personal protective equipment.
Natural and Emerging Solutions
For those seeking less toxic alternatives, certain natural compounds have shown promise in spore elimination. Essential oils like oregano, thyme, and cinnamon have demonstrated sporicidal properties, though their efficacy varies and often requires higher concentrations (e.g., 5–10% solutions) and longer exposure times. Additionally, emerging technologies such as cold plasma treatment offer a non-thermal, chemical-free method to destroy spores by generating reactive oxygen and nitrogen species. While still in experimental stages, these innovations hold potential for future applications in healthcare and food safety.
Practical Considerations and Limitations
Choosing the right alternative depends on the context and specific needs. For instance, heat sterilization is ideal for heat-resistant materials but impractical for heat-sensitive items. Chemical agents, while effective, may leave residues or damage certain surfaces. Natural methods, though appealing, often lack the consistency and speed of industrial solutions. It’s crucial to assess factors like cost, scalability, and environmental impact when selecting a method. For home use, boiling water or diluted hydrogen peroxide (3%) can be practical, but always follow manufacturer guidelines for safety and efficacy.
By understanding these alternatives, individuals and industries can make informed decisions to effectively eliminate spores, ensuring safety and hygiene in various settings. Each method has its strengths and limitations, making it essential to tailor the approach to the specific challenge at hand.
Troubleshooting Tips: Why You Can't Create an EA Account for Spore
You may want to see also
Frequently asked questions
Most antiseptics are not effective against bacterial spores. Spores have a highly resistant structure that allows them to survive harsh conditions, including exposure to many antiseptics.
Sporicidal agents, such as certain chemical sterilants like hydrogen peroxide or glutaraldehyde, are required to kill spores. Standard antiseptics like alcohol or iodine are generally ineffective against them.
Spores have a thick, protective outer layer called the spore coat and contain high levels of calcium dipicolinate, which makes them highly resistant to heat, chemicals, and desiccation, including most antiseptics.































